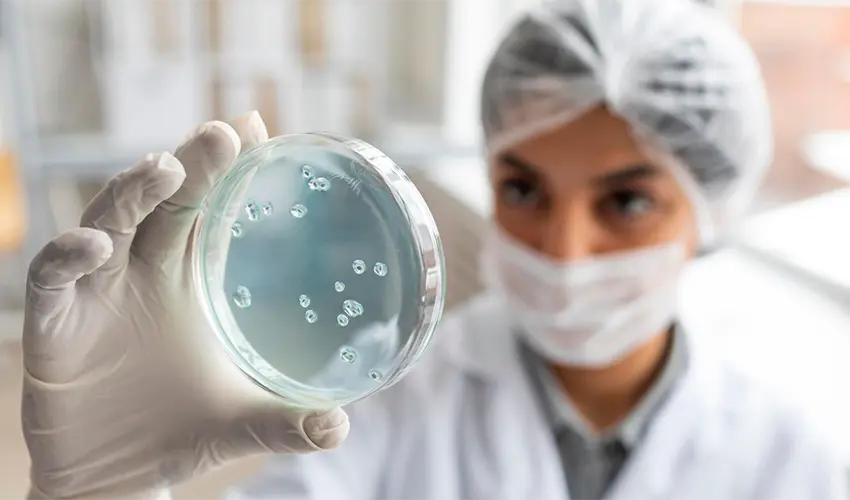
test-image-31

Microbiology
Culture & Sensitivity
Culture and sensitivity tests are performed to detect bacterial or fungal infections in different body fluids and tissues. They identify the microorganism causing infection and determine which antibiotics are most effective for treatment. These tests are essential for guiding targeted therapy, preventing complications, and reducing antibiotic resistance.
Included tests:
|
|
Body Fluid
Body fluid analysis plays a vital role in diagnosing infections, inflammations, cancers, and systemic diseases. Different fluids from the body are examined to assess cellular, chemical, and microbiological changes, helping physicians determine underlying medical conditions and guide appropriate treatment.
Included Tests:
-
CSF Fluid (Cerebrospinal Fluid): Analyzes the fluid surrounding the brain and spinal cord to detect infections (e.g., meningitis), bleeding, or neurological disorders.
-
Peritoneal Fluid: Examines fluid in the abdominal cavity to diagnose infections, liver disease (ascites), or cancer.
-
Synovial Fluid: Evaluates joint fluid to detect arthritis, gout, or infections.
-
Pleural Fluid: Analyzes fluid around the lungs to identify infections, heart failure, or malignancy.
-
Semen Analysis: Assesses sperm count, motility, and morphology; commonly used in fertility evaluation and reproductive health.

